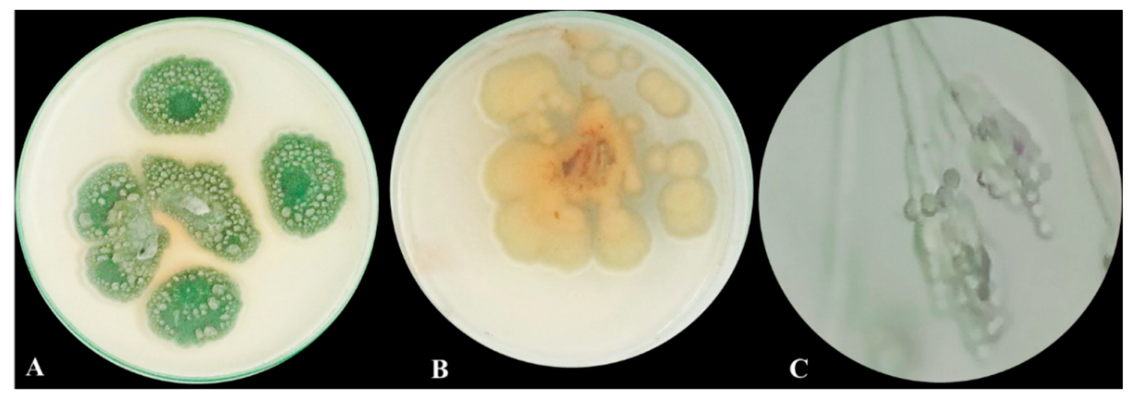

Acetylcholine Esterase Inhibitory Effect, Antimicrobial, Antioxidant, Metabolomic Profiling, and an In Silico Study of Non-Polar Extract of The Halotolerant Marine Fungus Penicillium chrysogenum MZ945518
Abstract
1. Introduction
2. Materials and Methods
2.1. The Fungal Culture Used
2.2. Halotolerance Test
2.3. Extraction of Fungal Metabolites
2.4. The Antimicrobial Effect Evaluation
2.4.1. The Reference Pathogens
2.4.2. Agar–Diffusion Technique
2.4.3. Screening of Antifungal Effect
2.5. Antioxidant Activity
2.5.1. Measurement of Free Radical Scavenging Activity
2.5.2. Ferric Reducing Antioxidant Power (FRAP) Assay
2.5.3. Metal Ion Chelating Activity
2.6. Acetylcholine Esterase Inhibitory Effect
2.7. Chemical Analysis
2.7.1. Determination of Total Phenolics and Flavinoids
2.7.2. Gas chromatography–Mass Spectrometry (GC–MS) Analysis
2.8. Molecular Modelling
2.8.1. Small Molecule Preparation
2.8.2. Protein Structure Selection
2.8.3. Analysis of Binding Sites
2.8.4. The Stepwise Docking Method of MOE
2.8.5. ADMET Profile
2.9. Statistical Analysis
3. Results
3.1. Morphological Macroscopic and Microscopic Characters of the Isolated Fungus
3.2. Halotolerance Test
3.3. Antimicrobial Activity
3.4. Antioxidant Activity
3.5. Acetylcholine Esterase Inhibitory Effect
3.6. Chemical Analysis
3.6.1. Total Phenolics and Flavonoids
3.6.2. GC/MS Profiling
3.7. Molecular Docking Study
3.8. ADMET Profile
4. Discussion
5. Conclusions
Author Contributions
Funding
Institutional Review Board Statement
Informed Consent Statement
Data Availability Statement
Acknowledgments
Conflicts of Interest
References
- Farias, D.F.; Souza, T.M.; Viana, M.P.; Soares, B.M.; Cunha, A.P.; Vasconcelos, I.M.; Ricardo, N.M.P.S.; Ferreira, P.M.P.; Melo, V.M.M.I.; Carvalho, A.F.U. Antibacterial, antioxidant, and anticholinesterase activities of plant seed extracts from Brazilian semiarid region. BioMed Res. Int. 2013, 2013, 510736. [Google Scholar] [CrossRef] [PubMed]
- Özcan, K.; Acet, T.; Çorbacı, C. Centaurea hypoleuca DC: Phenolic content, antimicrobial, antioxidant and enzyme inhibitory activities. S. Afr. J. Bot. 2019, 127, 313–318. [Google Scholar] [CrossRef]
- Schneider, Y.K. Bacterial natural product drug discovery for new antibiotics: Strategies for tackling the problem of antibiotic resistance by efficient bioprospecting. Antibiotics 2021, 10, 842. [Google Scholar] [CrossRef]
- Ameen, F.; AlNadhari, S.; Al-Homaidan, A.A. Marine Microorganisms as an Untapped Source of Bioactive Compounds. Saudi J. Biol. Sci. 2021, 28, 224–231. [Google Scholar] [CrossRef] [PubMed]
- Cicatiello, P.; Stanzione, I.; Dardano, P.; De Stefano, L.; Birolo, L.; De Chiaro, A.; Monti, D.M.; Petruk, G.; D’errico, G.; Giardina, P. Characterization of a Surface-Active Protein Extracted from a Marine Strain of Penicillium chrysogenum. Int. J. Mol. Sci. 2019, 20, 3242. [Google Scholar] [CrossRef]
- Romano, G.; Costantini, M.; Sansone, C.; Lauritano, C.; Ruocco, N.; Ianora, A. Marine Microorganisms as a Promising and Sustainable Source of Bioactive Molecules. Mar. Environ. Res. 2017, 128, 58–69. [Google Scholar] [CrossRef]
- Reen, F.J.; Gutiérrez-Barranquero, J.A.; Dobson, A.D.W.; Adams, C.; O’Gara, F. Emerging Concepts Promising New Horizons for Marine Biodiscovery and Synthetic Biology. Mar. Drugs 2015, 13, 2924–2954. [Google Scholar] [CrossRef]
- Gonçalves, M.F.M.; Santos, L.; Silva, B.M.V.; Abreu, A.C.; Vicente, T.F.L.; Esteves, A.C.; Alves, A. Biodiversity of Penicillium Species from Marine Environments in Portugal and Description of Penicillium lusitanum Sp. Nov., a Novel Species Isolated from Sea Water. Int. J. Syst. Evol. Microbiol. 2019, 69, 3014–3021. [Google Scholar] [CrossRef] [PubMed]
- Visagie, C.M.; Houbraken, J.; Frisvad, J.C.; Hong, S.B.; Klaassen, C.H.W.; Perrone, G.; Seifert, K.A.; Varga, J.; Yaguchi, T.; Samson, R.A. Identification and Nomenclature of the Genus Penicillium. Stud. Mycol. 2014, 78, 343–371. [Google Scholar] [CrossRef]
- Thorskov Bladt, T.; Frisvad, J.C.; Knudsen, P.B.; Larsen, T.O. Molecules Anticancer and Antifungal Compounds from Aspergillus, Penicillium and Other Filamentous Fungi. Molecules 2013, 18, 11338–11376. [Google Scholar] [CrossRef] [PubMed]
- Sikandar, A.; Zhang, M.; Wang, Y.; Zhu, X.; Liu, X.; Fan, H.; Xuan, Y.; Chen, L.; Duan, Y. Mycochemical Screening and Analysis, Antioxidant Activity, and Biochemical Composition of Fermentation Strain Snef1216 (Penicillium chrysogenum). J. Anal. Methods Chem. 2020, 2020, 3073906. [Google Scholar] [CrossRef]
- Boulis, A.G.; Hamed, A.A.; El-awady, M.E.; Mohamed, A.R.; Eliwa, E.M.; Asker, M.M.S.; Shaaban, M. Diverse Bioactive Metabolites from Penicillium Sp. MMA Derived from the Red Sea: Structure Identification and Biological Activity Studies. Arch. Microbiol. 2020, 202, 1985–1996. [Google Scholar] [CrossRef]
- Ziemons, S.; Koutsantas, K.; Becker, K.; Dahlmann, T.; Kück, U. Penicillin Production in Industrial Strain Penicillium chrysogenum P2niaD18 Is Not Dependent on the Copy Number of Biosynthesis Genes. BMC Biotechnol. 2017, 17, 16. [Google Scholar] [CrossRef]
- Scott, J.; Untereiner, W.A.; Wong, B.; Straus, N.A.; Malloch, D. Genotypic Variation in Penicillium chysogenum from Indoor Environ-Ments. Mycologia 2004, 96, 1095–1105. [Google Scholar] [CrossRef]
- Banke, S.; Frisvad, J.C.; Ahl, S.R. Taxonomy of Penicillium chrysogenum and Related Xerophilic Species, Based on Isozyme Analysis. Mycol. Res. 1997, 101, 617–624. [Google Scholar] [CrossRef]
- Rančić, A.; Soković, M.; Karioti, A.; Vukojević, J.; Skaltsa, H. Isolation and Structural Elucidation of Two Secondary Metabolites from the Filamentous Fungus Penicillium ochrochloron with Antimicrobial Activity. Environ. Toxicol. Pharmacol. 2006, 22, 80–84. [Google Scholar] [CrossRef]
- Morad, M.Y.; El-Sayed, H.; Elhenawy, A.A.; Korany, S.M.; Aloufi, A.S.; Ibrahim, A.M. Myco-Synthesized Molluscicidal and Larvicidal Selenium Nanoparticles: A New Strategy to Control Biomphalaria alexandrina Snails and Larvae of Schistosoma mansoni with an In Silico Study on Induced Oxidative Stress. J. Fungi 2022, 8, 262. [Google Scholar] [CrossRef] [PubMed]
- Frisvad, J.C. Halotolerant and halophilic fungi and their extrolite production. In Adaptation to Life at High Salt Concentrations in Ar-chaea, Bacteria, and Eukarya; Gunde-Cimerman, N., Oren, A., Plemenitaš, A., Eds.; Springer: Dordrecht, The Netherlands, 2005. [Google Scholar]
- Hamad, D.; El-Sayed, H.; Ahmed, W.; Sonbol, H.; Ramadan, M.A.H. GC-MS Analysis of Potentially Volatile Compounds of Pleurotus Ostreatus Polar Extract: In Vitro Antimicrobial, Cytotoxic, Immunomodulatory, and Antioxidant Activities. Front. Microbiol. 2022, 13, 525. [Google Scholar] [CrossRef] [PubMed]
- Naglah, A.M.; Moustafa, G.O.; Elhenawy, A.A.; Mounier, M.M.; El-Sayed, H.; Al-Omar, M.A.; Almehizia, A.A.; Bhat, M.A. Nα-1, 3-Benzenedicarbonyl-Bis-(Amino Acid) and Dipeptide Candidates: Synthesis, Cytotoxic, Antimicrobial and Molecular Docking Investigation. Drug Des Devel Ther. 2021, 2021, 1315–1332. [Google Scholar] [CrossRef] [PubMed]
- Boly, R.; Lamkami, T.; Lompo, M.; Dubois, J.; Guissou, I. DPPH Free Radical Scavenging Activity of Two Extracts from Agelanthus Dodoneifolius (Loranthaceae) Leaves. Int. J. Toxicol. Pharmacol. Res. 2016, 29–34. [Google Scholar]
- Benzie, I.F.F.; Strain, J.J. The Ferric Reducing Ability of Plasma (FRAP) as a Measure of “Antioxidant Power”: The FRAP Assay. Anal. Biochem. 1996, 239, 70–76. [Google Scholar] [CrossRef] [PubMed]
- Santos, J.S.; Alvarenga Brizola, V.R.; Granato, D. High-Throughput Assay Comparison and Standardization for Metal Chelating Capacity Screening: A Proposal and Application. Food Chem. 2017, 214, 515–522. [Google Scholar] [CrossRef]
- Kia, Y.; Osman, H.; Kumar, R.S.; Basiri, A.; Murugaiyah, V. Ionic Liquid Mediated Synthesis of Mono- and Bis-Spirooxindole-Hexahydropyrrolidines as Cholinesterase Inhibitors and Their Molecular Docking Studies. Bioorg. Med. Chem. 2014, 22, 1318–1328. [Google Scholar] [CrossRef]
- Kujala, T.S.; Loponen, J.M.; Klika, K.D.; Pihlaja, K. Phenolics and Betacyanins in Red Beetroot (Beta vulgaris) Root: Distribution and Effect of Cold Storage on the Content of Total Phenolics and Three Individual Compounds. J. Agric. Food Chem. 2000, 48, 5338–5342. [Google Scholar] [CrossRef] [PubMed]
- Zhishen, J.; Mengcheng, T.; Jianming, W. The Determination of Flavonoid Contents in Mulberry and Their Scavenging Effects on Superoxide Radicals. Food Chem. 1999, 64, 555–559. [Google Scholar] [CrossRef]
- Molecular Operating Environment (MOE); v. 2019.01; Chemical Computing Group ULC: Montreal, QC, Canada, 2021; Available online: https://www.chemcomp.com/Products.htm (accessed on 12 March 2023).
- Hu, Y.; Shi, H.; Zhou, M.; Ren, Q.; Zhu, W.; Zhang, W.; Zhang, Z.; Zhou, C.; Liu, Y.; Ding, X.; et al. Discovery of Pyrido[2,3- b]Indole Derivatives with Gram-Negative Activity Targeting Both DNA Gyrase and Topoisomerase IV. J. Med. Chem. 2020, 63, 9623–9649. [Google Scholar] [CrossRef]
- Gocheva, Y.; Angelova, M.; Krumova, E. Potential of Halotolerant and Halophilic Fungi as a Source of New Extracellular Enzymes and Antimicrobial Compounds. Acta Microbiol. Bulg. V 2021, 37, 57–67. [Google Scholar]
- Tiwari, K.L.; Jadhav, S.K.; Kumar, A. Morphological and Molecular Study of Different Penicillium Species. Middle East J. Sci. Res. 2011, 7, 203–210. [Google Scholar]
- Tashpulatov, Z.; Baibaev, B.G. Chemical Composition of Mycelium of the Thermotolerant Fungus Penicillium atrovenetum. Chem. Nat. Compd. 2000, 36, 518–520. [Google Scholar] [CrossRef]
- Lotlikar, N.; Damare, S.; Meena, R.M.; Jayachandran, S. Variable Protein Expression in Marine-Derived Filamentous Fungus: Penicillium chrysogenum in Response to Varying Copper Concentrations and Salinity. Metallomics 2020, 12, 1083–1093. [Google Scholar] [CrossRef] [PubMed]
- Boucherit, Z.; Flahaut, S.; Djoudi, B.; Mouas, T.-N.; Mechakra, A.; Ameddah, S. Potential of Halophilic Penicillium chrysogenum Isolated from Algerian Saline Soil to Produce Laccase on Olive Oil Wastes. Curr. Microbiol. 2022, 79, 178. [Google Scholar] [CrossRef]
- Schaffer, J.N.; Pearson, M.M. Proteus mirabilis and urinary tract infections. In Urinary Tract Infections: Molecular Pathogenesis and Clinical Management; John and Wily and Sons: Hoboken, NJ, USA, 2016. [Google Scholar]
- Chen, C.Y.; Chen, Y.H.; Lu, P.L.; Lin, W.R.; Chen, T.C.; Lin, C.Y. Proteus Mirabilis Urinary Tract Infection and Bacteremia: Risk Factors, Clinical Presentation, and Outcomes. J. Microbiol. Immunol. Infect. 2012, 45, 228–236. [Google Scholar] [CrossRef] [PubMed]
- Ababutain, I.M.; Aldosary, S.K.; Aljuraifani, A.A.; Alghamdi, A.I.; Alabdalall, A.H.; Al-Khaldi, E.M.; Aldakeel, S.A.; Almandil, N.B.; Abdulazeez, S.; Francis Borgio, J. Identification and Antibacterial Characterization of Endophytic Fungi from Artemisia sieberi. Hindawi Int. J. Microbiol. 2021, 2021, 11. [Google Scholar] [CrossRef]
- Attia, E.Z.; Khalifa, B.A.; Shaban, G.M.; Abdelraheem, W.M.; Mustafa, M.; Abdelmohsen, U.R.; El-Katatny, M.H. Discovering the Chemical Profile, Antimicrobial and Antibiofilm Potentials of the Endophytic Fungus Penicillium chrysogenum Isolated from Artemisia judaica, L. Assisted with Docking Studies. S. Afr. J. Bot. 2022, 151, 218–227. [Google Scholar] [CrossRef]
- Lopes, F.C.; Tichota, D.M.; Sauter, I.P.; Meira, S.M.; Segalin, J.; Rott, M.B.; Rios, A.O.; Brandelli, A. Active metabolites produced by Penicillium chrysogenum IFL1 growing on agro-industrial residues. Annals of microbiology. 2013, 63, 771–778. [Google Scholar] [CrossRef]
- Khan, I.; Zhang, H.; Liu, W.; Zhang, L.; Peng, F.; Chen, Y.; Zhang, Q.; Zhang, G.; Zhang, W.; Zhang, C. Identification and Bioactivity Evaluation of Secondary Metabolites from Antarctic-Derived Penicillium chrysogenum CCTCC M 2020019. RSC Adv. 2020, 10, 20738–20744. [Google Scholar] [CrossRef]
- Subramani, R.; Kumar, R.; Prasad, P.; Aalbersberg, W. Cytotoxic and Antibacterial Substances against Multi-Drug Resistant Pathogens from Marine Sponge Symbiont: Citrinin, a Secondary Metabolite of Penicillium sp. Asian Pac. J. Trop. Biomed. 2013, 3, 291–296. [Google Scholar] [CrossRef] [PubMed]
- Mahalingam, S.S.; Jayaraman, S.; Pandiyan, P. Fungal Colonization and Infections-Interactions with Other Human Diseases. Pathogens 2022, 11, 212. [Google Scholar] [CrossRef] [PubMed]
- Al-Saleem, M.S.M.; Hassan, W.H.B.; El Sayed, Z.I.; Abdel-Aal, M.M.; Abdel-Mageed, W.M.; Abdelsalam, E.; Abdelaziz, S. Metabolic Profiling and In Vitro Assessment of the Biological Activities of the Ethyl Acetate Extract of Penicillium Chrysogenum “Endozoic of Cliona Sp. Marine Sponge” from the Red Sea (Egypt). Mar. Drugs 2022, 20, 326. [Google Scholar] [CrossRef] [PubMed]
- Nag, P.; Paul, S.; Shriti, S.; Das, S. Defence Response in Plants and Animals against a Common Fungal Pathogen, Fusarium Oxysporum. Curr. Res. Microb. Sci. 2022, 3, 100135. [Google Scholar] [CrossRef]
- Ajayi-Oyetunde, O.O.; Bradley, C.A. Rhizoctonia Solani: Taxonomy, Population Biology and Management of Rhizoctonia Seedling Disease of Soybean. Plant Pathol. 2018, 67, 3–17. [Google Scholar] [CrossRef]
- Wang, S.Y.; Herrera-Balandrano, D.D.; Wang, Y.X.; Shi, X.C.; Chen, X.; Jin, Y.; Liu, F.Q.; Laborda, P. Biocontrol Ability of the Bacillus amyloliquefaciens Group, B. amyloliquefaciens, B. velezensis, B. nakamurai, and B. siamensis, for the Management of Fungal Postharvest Diseases: A Review. J. Agric. Food Chem. 2022, 70, 6591–6616. [Google Scholar] [CrossRef]
- Wang, X.; Liang, L.; Shao, H.; Ye, X.; Yang, X.; Chen, X.; Shi, Y.; Zhang, L.; Xu, L.; Wang, J. Isolation of the Novel Strain Bacillus amyloliquefaciens F9 and Identification of Lipopeptide Extract Components Responsible for Activity against Xanthomonas citri Subsp. Citri. Plants 2022, 11, 457. [Google Scholar] [CrossRef] [PubMed]
- Ahmed, H.F.A.; Seleiman, M.F.; Al-Saif, A.M.; Alshiekheid, M.A.; Battaglia, M.L.; Taha, R.S. Biological Control of Celery Powdery Mildew Disease Caused by Erysiphe Heraclei Dc in Vitro and in Vivo Conditions. Plants 2021, 10, 2342. [Google Scholar] [CrossRef] [PubMed]
- Sonderegger, C.; Galgóczy, L.; Garrigues, S.; Fizil, Á.; Borics, A.; Manzanares, P.; Hegedüs, N.; Huber, A.; Marcos, J.F.; Batta, G.; et al. A Penicillium Chrysogenum-Based Expression System for the Production of Small, Cysteine-Rich Antifungal Proteins for Structural and Functional Analyses. Microb. Cell Fact 2016, 15, 192. [Google Scholar] [CrossRef] [PubMed]
- Binder, U.; Chu, M.; Read, N.D.; Marx, F. The Antifungal Activity of the Penicillium Chrysogenum Protein PAF Disrupts Calcium Homeostasis in Neurospora Crassa. Eukaryot. Cell 2010, 9, 1374–1382. [Google Scholar] [CrossRef]
- Hong, S.; Kim, T.Y.; Won, S.J.; Moon, J.H.; Ajuna, H.B.; Kim, K.Y.; Ahn, Y.S. Control of Fungal Diseases and Fruit Yield Improvement of Strawberry Using Bacillus velezensis CE 100. Microorganisms 2022, 10, 365. [Google Scholar] [CrossRef] [PubMed]
- Wang, J.; Cai, B.; Li, K.; Zhao, Y.; Li, C.; Liu, S.; Xiang, D.; Zhang, L.; Xie, J.; Wang, W. Biological Control of Fusarium oxysporum f. Sp. Cubense Tropical Race 4 in Banana Plantlets Using Newly Isolated Streptomyces Sp. WHL7 from Marine Soft Cora. Plant Dis. 2022, 106, 254–259. [Google Scholar] [CrossRef]
- Ebrahimi-Zarandi, M.; Bonjar, G.H.S.; Riseh, R.S.; El-Shetehy, M.; Saadoun, I.; Barka, E.A. Exploring Two Streptomyces Species to Control Rhizoctonia Solani in Tomato. Agronomy 2021, 11, 1384. [Google Scholar] [CrossRef]
- Abbas, A.; Khan, S.U.; Khan, W.U.; Saleh, T.A.; Khan, M.H.U.; Ullah, S.; Ali, A.; Ikram, M. Antagonist Effects of Strains of Bacillus Spp. against Rhizoctonia Solani for Their Protection against Several Plant Diseases: Alternatives to Chemical Pesticides. CR Biol. 2019, 342, 124–135. [Google Scholar] [CrossRef]
- Yamagishi, S.I.; Matsui, T. Nitric Oxide, a Janus-Faced Therapeutic Target for Diabetic Microangiopathy—Friend or Foe? Pharmacol. Res. 2011, 64, 187–194. [Google Scholar] [CrossRef]
- Wu, Y.-Y.; Li, W.; Xu, Y.; Jin, E.-H.; Tu, Y.-Y. Evaluation of the Antioxidant Effects of Four Main Theaflavin Derivatives through Chemiluminescence and DNA Damage Analyses. J Zhejiang Univ. Sci. B 2011, 12, 744–751. [Google Scholar] [CrossRef] [PubMed]
- Lima, M.T.N.S.; dos Santos, L.B.; Bastos, R.W.; Nicoli, J.R.; Takahashi, J.A. Antimicrobial Activity and Acetylcholinesterase Inhibition by Extracts from Chromatin Modulated Fungi. Braz. J. Microbiol. 2018, 49, 169–176. [Google Scholar] [CrossRef] [PubMed]
- Kurashov, E.A.; Fedorova, E.V.; Krylova, J.V.; Mitrukova, G.G. Assessment of the Potential Biological Activity of Low Molecular Weight Metabolites of Freshwater Macrophytes with QSAR. Scientifica 2016, 2016, 1205680. [Google Scholar] [CrossRef] [PubMed]
- Ivanova, E.P.; Nguyen, S.H.; Guo, Y.; Baulin, V.A.; Webb, H.K.; Truong, V.K.; Wandiyanto, J.V.; Garvey, C.J.; Mahon, P.J.; Mainwaring, D.E.; et al. Bactericidal Activity of Self-Assembled Palmitic and Stearic Fatty Acid Crystals on Highly Ordered Pyrolytic Graphite. Acta Biomater. 2017, 59, 148–157. [Google Scholar] [CrossRef] [PubMed]
- García-Cazorla, Y.; Getino, M.; Sanabria-Ríos, D.J.; Carballeira, N.M.; de La Cruz, F.; Arechaga, I.; Cabezón, E. Conjugation Inhibitors Compete with Palmitic Acid for Binding to the Conjugative Traffic ATPase TrwD, Providing a Mechanism to Inhibit Bacterial Conjugation. J. Biol. Chem. 2018, 293, 16923–16930. [Google Scholar] [CrossRef]
- Saeed, N.M.; El-Demerdash, E.; Abdel-Rahman, H.M.; Algandaby, M.M.; Al-Abbasi, F.A.; Abdel-Naim, A.B. Anti-Inflammatory Activity of Methyl Palmitate and Ethyl Palmitate in Different Experimental Rat Models. Toxicol. Appl. Pharmacol. 2012, 264, 84–93. [Google Scholar] [CrossRef]
- Lu, Q.; Liu, T.; Wang, N.; Dou, Z.; Wang, K.; Zuo, Y. Nematicidal Effect of Methyl Palmitate and Methyl Stearate against Meloidogyne Incognita in Bananas. J. Agric. Food Chem. 2020, 68, 6502–6510. [Google Scholar] [CrossRef] [PubMed]
- El-Demerdash, E. Anti-Inflammatory and Antifibrotic Effects of Methyl Palmitate. Toxicol. Appl. Pharmacol. 2011, 254, 238–244. [Google Scholar] [CrossRef] [PubMed]
- Hadi, M.Y.; Mohammed, G.J.; Hameed, I.H. Analysis of Bioactive Chemical Compounds of Nigella Sativa Using Gas Chromatography-Mass Spectrometry. J. Pharmacogn. Phytother. 2016, 8, 8–24. [Google Scholar] [CrossRef]
- Ojuolape Amusan, T. Phytochemical, Antidiarrhoeal Activity, Isolation and Characterisation of 11-Octadecenoic Acid, Methyl Ester Isolated from the Seeds of Acacia Nilotica Linn. J. Biotechnol. Immunol. 2020, 2. Available online: https://escientificpublishers.com/phytochemical-antidiarrhoeal-activity-isolation-and-characterisation-of-11-octadecenoic-acid (accessed on 10 March 2023).
- Zeatar, A.; Abou Elenaina, I.; Zayed, A.; Mahmoud, Y.; Elkhawaga, M. Screening and Identification of Actinomycetes from Animals’ Dung for Antimicrobial Activity. Delta J. Sci. 2022, 44, 35–56. [Google Scholar] [CrossRef]
- Han, W.; Cai, J.; Zhong, W.; Xu, G.; Wang, F.; Tian, X.; Zhou, X.; Liu, Q.; Liu, Y.; Wang, J. Protein Tyrosine Phosphatase 1B (PTP1B) Inhibitors from the Deep-Sea Fungus Penicillium chrysogenum SCSIO 07007. Bioorg. Chem. 2020, 96, 103646. [Google Scholar] [CrossRef]
- Ragavendran, C.; Manigandan, V.; Kamaraj, C.; Balasubramani, G.; Prakash, J.S.; Perumal, P.; Natarajan, D. Larvicidal, Histopathological, Antibacterial Activity of Indigenous Fungus Penicillium Sp. Against Aedes Aegypti L and Culex quinquefasciatus (Say) (Diptera: Culicidae) and Its Acetylcholinesterase Inhibition and Toxicity Assessment of Zebrafish (Danio rerio). Front. Microbiol. 2019, 10, 427. [Google Scholar] [CrossRef]
- Taqui, R.; Debnath, M.; Ahmed, S.; Ghosh, A. Advances on Plant Extracts and Phytocompounds with Acetylcholinesterase Inhibition Activity for Possible Treatment of Alzheimer’s Disease. Phytomed. Plus 2022, 2, 100184. [Google Scholar] [CrossRef]
- Rasmussen, J.; Langerman, H. Alzheimer’s Disease—Why We Need Early Diagnosis. Degener. Neurol. Neuromuscul. Dis. 2019, 2019, 123–130. [Google Scholar] [CrossRef]
- Wang, S.; Kong, X.; Chen, Z.; Wang, G.; Zhang, J.; Wang, J. Role of Natural Compounds and Target Enzymes in the Treatment of Alzheimer’s Disease. Molecules 2022, 27, 4175. [Google Scholar] [CrossRef] [PubMed]
- Olsen, E.K.; Hansen, E.; Moodie, L.W.; Isaksson, J.; Sepčić, K.; Cergolj, M.; Svenson, J.; Andersen, J.H. Marine AChE Inhibitors Isolated from Geodia Barretti: Natural Compounds and Their Synthetic Analogs. Org. Biomol. Chem. 2016, 14, 1629–1640. [Google Scholar] [CrossRef] [PubMed]
- Bajda, M.; Wiȩckowska, A.; Hebda, M.; Guzior, N.; Sotriffer, C.A.; Malawska, B. Structure-Based Search for New Inhibitors of Cholinesterases. Int. J. Mol. Sci. 2013, 14, 5608. [Google Scholar] [CrossRef] [PubMed]
- Amat-Ur-rasool, H.; Ahmed, M.; Hasnain, S.; Ahmed, A.; Carter, W.G. In Silico Design of Dual-Binding Site Anti-Cholinesterase Phytochemical Heterodimers as Treatment Options for Alzheimer’s Disease. Curr. Issues Mol. Biol. 2022, 44, 12. [Google Scholar] [CrossRef] [PubMed]

| Microbial Pathogens | Inhibition Clear Zone Diameter (Mm) | |||
|---|---|---|---|---|
| P. Chrysogenum Extract | Gentamycin (10 μg/disc) | Amphotericin B (100 units/disc) | ||
| Gram-positive bacteria | Staphylococcus aureus ATCC25923 | 11 ± 0.2 | 21 ± 0.2 | Nt |
| Micrococcus luteus ATCC 9341 | 20 ± 0.6 * | 18 ± 0.1 | Nt | |
| Streptococcus pneumoniae ATCC49619 | 14 ± 0.8 | 15 ± 0.5 | Nt | |
| Gram-negative bacteria | Escherichia coli ATCC25922 | 20 ± 0.0 # | 25 ± 0.8 | Nt |
| Pseudomonas aeruginosa ATCC 7853 | 13 ± 0.5 | 20 ± 0.6 | Nt | |
| Proteus mirabilis ATCC29906 | 12 ± 0.2 * | 10 ± 0.0 | Nt | |
| Pathogenic yeast | Candida albicans ATCC 20231 | 15 ± 0.1 | Nt | 20 ± 0.5 |
| Percent of Inhibition of Mycelial Growth (PIMG) % | ||
|---|---|---|
| Rhizoctonia solani | Fusarium oxysporum | Fusarium solani |
| 52 ± 0.0 | 40 ± 0.5 | 77.5 ± 0.3 |
| DPPH IC50 (μg/mL) | FRAP (μM Trolox eq/mg Extract) | MIC (μM EDTA eq/mg Extract) | |
|---|---|---|---|
| Fungus extract | 542.5± 69.1 | 57.9 ± 4.6 | 12.7 ± 0.9 |
| Trolox | 24.4 ± 0.8 |
| % Inhibition 100 μg/mL | IC50 (μg/mL) | |
|---|---|---|
| fungus extract | 63.32 ± 2.88 | 60.87 ± 3.81 |
| Donepezil | 3.4 ± 0.32 |
| Compound Name | Chemical Formula | Molecular Weight (g/mol) | Retention Time (min) | Area % | |
|---|---|---|---|---|---|
| 1 | Glyceryl acetate | C5H10O4 | 134 | 12.22 | 0.41 |
| 2 | Glycerol 1,2-diacetate | C7H12O5 | 176 | 12.54 | 1.20 |
| 3 | 1,5-Anhydroglucitol | C6H12O5 | 164 | 12.59 | 1.50 |
| 4 | 2,3-dihydroxypropyl acetate | C5H10O4 | 134 | 13.25 | 5.32 |
| 5 | 1,2,3-Propanetriol triacetate | C9H14O6 | 218 | 13.57 | 0.66 |
| 6 | 2,3-bis (Acetyloxy)-1-[(acetyloxy)methyl] propylacetate | C12H18O8 | 290 | 14.55 | 1.62 |
| 7 | Methyl palmitate | C17H34O2 | 270 | 20.43 | 1.83 |
| 8 | n-Hexadecanoic acid (palmitic acid) | C16H32O2 | 256 | 21.49 | 7.80 |
| 9 | 5,7-dimethoxy-1-Naphthalenol, | C12H12O3 | 204 | 21.86 | 1.19 |
| 10 | 4,4,8a-Trimethyl-7-methylidene-8-[(2E)-3-methylpenta-2,4-dienyl]-2,3,4a,5,6,8-hexahydro-1H-naphthalene (Biformen) | C20H32 | 272 | 22.87 | 0.88 |
| 11 | 9,12-Octadecadienoic acid (Z, Z)-, methyl ester | C19H34O2 | 294 | 23.05 | 4.81 |
| 12 | 11-Octadecenoic acid, methyl ester | C19H36O2 | 296 | 23.15 | 2.91 |
| 13 | Methyl stearate | C19H38O2 | 298 | 23.56 | 0.77 |
| 14 | (Z)-18-Octadec-9-enolide | C18H32O2 | 280 | 24.21 | 36.28 |
| 15 | Octadecanoic acid | C18H36O2 | 284 | 24.46 | 1.79 |
| 16 | [1,1’-Bicyclopropyl]-2-octanoic acid, 2’-hexyl-, methyl ester 56687-68-4 DTXSID301016055 2’-Hexyl-1,1’-bicyclopropane-2-octanoic acid methyl ester | C21H38O2 | 322 | 25.97 | 0.46 |
| 17 | Hexanedioic acid, bis(2-ethylhexyl) ester | C22H42O4 | 370 | 27.37 | 0.34 |
| 18 | 1,2- Benzenedicarboxylic acid | C24H38O4 | 390 | 29.39 | 26.73 |
| 19 | 1-Heptatriacotanol | C37H76O | 536 | 30.26 | 0.29 |
| 20 | Butyl 9,12,15-octadecatrienoate | C22H38O2 | 444 | 30.86 | 3.22 |
| ΔG | rmsd | E.vdw | E.Int | E.H.B | ΔG | Rmsd | E.vdw | E.Int | E.H.B | ΔG | rmsd | E.vdw | E.Int | E.H.B | |
|---|---|---|---|---|---|---|---|---|---|---|---|---|---|---|---|
| 6M1J | 13GS | 1ACJ | |||||||||||||
| 1 | −4.81 | 1.47 | −7.21 | −43.20 | −8.70 | −4.81 | 1.46 | −9.43 | −5.83 | 2.47 | −4.95 | 1.16 | −9.58 | −8.59 | −9.70 |
| 2 | −7.78 | 1.63 | 38.65 | −16.40 | −8.11 | −7.78 | 1.16 | −6.77 | 20.65 | 1.63 | −8.34 | 141 | 9.33 | −13.12 | −5.96 |
| 3 | −5.08 | 1.29 | 75.79 | −50.89 | −12.08 | −5.08 | 1.22 | −3.81 | 94.18 | 1.29 | −8.44 | 1.87 | 23.75 | −19.11 | −8.32 |
| 4 | −5.14 | 1.24 | −7.81 | −51.91 | −9.07 | −5.14 | 1.30 | −3.06 | 467.93 | 2.24 | −8.72 | 1.07 | 27.24 | −9.68 | −7.02 |
| 5 | −6.60 | 1.62 | 34.15 | −41.51 | −9.74 | −6.60 | 0.96 | −9.61 | −1.21 | 1.62 | −5.05 | 1.89 | −8.36 | −10.65 | −9.55 |
| 6 | −7.33 | 1.33 | 20.53 | −57.93 | −9.28 | −7.33 | 1.55 | −7.88 | 17.57 | 1.33 | −5.83 | 0.86 | −36.81 | −12.70 | −9.18 |
| 7 | −6.52 | 1.26 | 151.64 | −56.57 | −11.23 | −6.52 | 1.77 | −8.01 | 22.37 | 1.26 | −7.72 | 1.41 | 28.78 | −15.85 | −10.59 |
| 8 | −7.76 | 1.43 | 28.39 | −41.65 | −9.06 | −7.76 | 1.95 | −9.56 | 148.97 | 1.43 | −8.31 | 1.86 | 28.54 | −14.61 | −8.72 |
| 9 | −6.13 | 1.65 | −74.75 | −47.34 | −8.27 | −6.13 | 1.38 | −6.13 | 25.10 | 1.65 | −6.80 | 1.26 | 170.25 | −17.94 | −9.60 |
| 10 | −4.72 | 1.76 | −4.69 | −45.57 | −8.96 | −4.72 | 1.38 | −7.07 | −75.53 | 2.76 | −8.80 | 1.03 | 30.61 | −12.23 | −4.94 |
| 11 | −4.64 | 1.42 | −5.24 | −49.54 | −9.79 | −4.64 | 1.21 | −8.50 | −6.66 | 1.42 | −8.54 | 1.17 | 37.63 | −12.92 | −6.88 |
| 12 | −4.62 | 1.42 | −8.33 | −49.96 | −9.07 | −4.62 | 1.66 | −7.12 | 16.17 | 4.42 | −5.84 | 1.76 | −4.40 | −15.34 | −9.33 |
| 13 | −4.56 | 1.10 | −7.04 | −43.75 | −8.71 | −4.56 | 1.30 | −3.06 | 467.93 | 2.10 | −8.28 | 1.88 | 36.96 | −16.97 | −9.04 |
| 14 | −4.84 | 1.02 | 74.63 | −57.86 | −11.22 | −4.84 | 1.17 | −11.10 | 87.17 | 2.02 | −7.71 | 1.28 | 61.95 | 0.03 | −1.18 |
| 15 | −4.77 | 1.88 | 77.57 | −51.50 | −11.51 | −4.77 | 1.53 | −8.91 | −7.16 | 1.88 | −5.34 | 1.90 | 73.59 | −12.84 | −9.40 |
| 16 | −4.70 | 1.61 | 73.16 | −65.51 | −11.22 | −4.70 | 1.82 | −7.60 | −44.23 | 2.61 | −8.25 | 1.23 | −2.90 | −9.71 | −5.77 |
| 17 | −5.14 | 2.24 | −7.81 | −51.91 | −9.07 | −5.14 | 1.45 | −8.58 | 16.83 | 2.24 | −7.58 | 1.67 | 33.96 | −19.36 | −11.18 |
| 18 | −5.13 | 1.92 | −6.97 | −52.68 | −10.11 | −5.13 | 1.86 | −7.31 | 24.00 | 0.92 | −6.77 | 1.92 | 155.01 | −25.88 | −9.63 |
| 19 | −4.84 | 1.44 | −5.89 | −47.97 | −8.69 | −4.84 | 1.00 | −10.09 | 152.42 | 1.44 | −7.96 | 1.67 | 29.16 | −17.06 | −9.26 |
| 20 | −4.79 | 1.10 | −8.82 | −47.96 | −8.68 | −4.79 | 1.41 | −6.41 | 19.07 | 1.10 | −6.83 | 0.90 | 44.70 | −22.36 | −8.49 |
| Compd. No | Lipinski Parameters | nROTB e | TPSA f | ABS% g | BBB h | GI ABS i | ||||
|---|---|---|---|---|---|---|---|---|---|---|
| MW a | HBA b | HBD c | LogP d | Violations | ||||||
| 1 | 134.13 | 4 | 2 | −3.83 | 0 | 4 | 66.76 | 85.97 | High | No |
| 2 | 176.17 | 5 | 1 | −3.6 | 0 | 6 | 72.83 | 83.87 | High | No |
| 3 | 164.16 | 5 | 4 | −3.13 | 0 | 1 | 90.15 | 77.90 | Low | No |
| 4 | 134.13 | 4 | 2 | −3.83 | 0 | 4 | 66.76 | 85.97 | High | No |
| 5 | 218.2 | 6 | 0 | −3.45 | 0 | 8 | 78.9 | 81.78 | High | No |
| 6 | 708.7 | 18 | 0 | −2.05 | 2 | 32 | 228.86 | 30.04 | Low | No |
| 7 | 270.45 | 2 | 0 | −2.71 | 1 | 15 | 26.3 | 99.93 | High | Yes |
| 8 | 256.42 | 2 | 1 | −2.77 | 1 | 14 | 37.3 | 96.13 | High | Yes |
| 9 | 144.17 | 1 | 1 | −2.16 | 0 | 0 | 20.23 | 102.02 | High | Yes |
| 10 | 272.47 | 0 | 0 | −2.86 | 1 | 3 | 0 | 109.00 | Low | No |
| 11 | 294.47 | 2 | 0 | −2.86 | 1 | 15 | 26.3 | 99.93 | Low | No |
| 12 | 296.49 | 2 | 0 | −2.82 | 1 | 16 | 26.3 | 99.93 | High | No |
| 13 | 298.5 | 2 | 0 | −2.19 | 1 | 17 | 26.3 | 99.93 | High | No |
| 14 | 280.45 | 2 | 0 | −3.32 | 1 | 0 | 26.3 | 99.93 | High | Yes |
| 15 | 284.48 | 2 | 1 | −2.19 | 1 | 16 | 37.3 | 96.13 | High | No |
| 16 | 322.53 | 2 | 0 | −2.57 | 1 | 15 | 26.3 | 99.93 | High | No |
| 17 | 370.57 | 4 | 0 | −3.7 | 1 | 19 | 52.6 | 90.85 | High | No |
| 18 | 728.69 | 18 | 10 | −2.11 | 3 | 18 | 338.86 | 7.91 | Low | No |
| 19 | 537 | 1 | 1 | 3.55 | 2 | 35 | 20.23 | 102.02 | Low | No |
| 20 | 334.54 | 2 | 0 | −3.05 | 1 | 17 | 26.3 | 99.93 | Low | No |
Disclaimer/Publisher’s Note: The statements, opinions and data contained in all publications are solely those of the individual author(s) and contributor(s) and not of MDPI and/or the editor(s). MDPI and/or the editor(s) disclaim responsibility for any injury to people or property resulting from any ideas, methods, instructions or products referred to in the content. |
© 2023 by the authors. Licensee MDPI, Basel, Switzerland. This article is an open access article distributed under the terms and conditions of the Creative Commons Attribution (CC BY) license (https://creativecommons.org/licenses/by/4.0/).
Share and Cite
El-Sayed, H.; Hamada, M.A.; Elhenawy, A.A.; Sonbol, H.; Abdelsalam, A. Acetylcholine Esterase Inhibitory Effect, Antimicrobial, Antioxidant, Metabolomic Profiling, and an In Silico Study of Non-Polar Extract of The Halotolerant Marine Fungus Penicillium chrysogenum MZ945518. Microorganisms 2023, 11, 769. https://doi.org/10.3390/microorganisms11030769
El-Sayed H, Hamada MA, Elhenawy AA, Sonbol H, Abdelsalam A. Acetylcholine Esterase Inhibitory Effect, Antimicrobial, Antioxidant, Metabolomic Profiling, and an In Silico Study of Non-Polar Extract of The Halotolerant Marine Fungus Penicillium chrysogenum MZ945518. Microorganisms. 2023; 11(3):769. https://doi.org/10.3390/microorganisms11030769
Chicago/Turabian StyleEl-Sayed, Heba, Marwa A. Hamada, Ahmed A. Elhenawy, Hana Sonbol, and Asmaa Abdelsalam. 2023. "Acetylcholine Esterase Inhibitory Effect, Antimicrobial, Antioxidant, Metabolomic Profiling, and an In Silico Study of Non-Polar Extract of The Halotolerant Marine Fungus Penicillium chrysogenum MZ945518" Microorganisms 11, no. 3: 769. https://doi.org/10.3390/microorganisms11030769
APA StyleEl-Sayed, H., Hamada, M. A., Elhenawy, A. A., Sonbol, H., & Abdelsalam, A. (2023). Acetylcholine Esterase Inhibitory Effect, Antimicrobial, Antioxidant, Metabolomic Profiling, and an In Silico Study of Non-Polar Extract of The Halotolerant Marine Fungus Penicillium chrysogenum MZ945518. Microorganisms, 11(3), 769. https://doi.org/10.3390/microorganisms11030769

